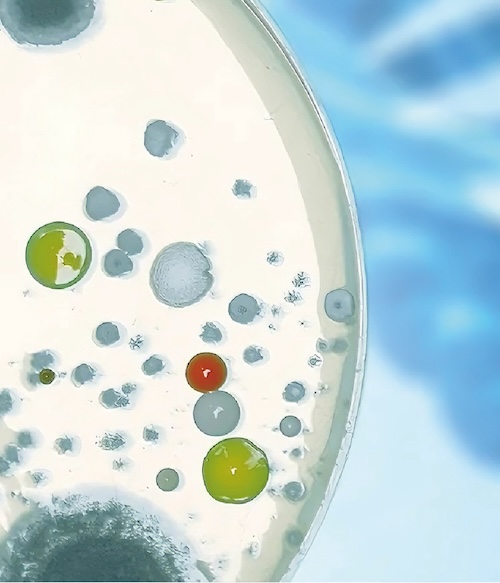

华安生物抗体产品
研究领域
抗体与生命科学研究
抗体可以高度特异性地与无限数量的靶蛋白结合。1900 年,Paul Ehrlich 将抗体称为“神奇子弹”。抗体由于其独特的特异性而被用于各种研究。由于其高选择性和特异性,它们广泛应用于生物医学研究,主要是治疗学、诊断学和许多其他领域。抗体用于识别未知分子并了解各种生化途径。广泛使用的实验室技术,如酶联免疫吸附测定(ELISA)、放射免疫测定(RIA)、共聚焦显微镜、电子显微镜、蛋白质印迹、免疫组织化学(IHC)、流式细胞术等,都是基于抗体的。单克隆抗体用于输送放射性同位素、毒素、细胞因子和其他活性缀合物。
抗体在各种研究技术中的应用
各种癌症相关研究都需要一抗(单克隆抗体或多克隆抗体)。例如,它们有助于了解炎症、转移、增殖信号、细胞凋亡、自噬、代谢、肿瘤抑制因子等。这些抗体也是研究干细胞如内皮干细胞标记物(例如 CD14、CD31、CD33)所必需的。 特定的重组表观遗传学抗体用于进行表观遗传学研究。一抗还用于蛋白质运输、神经发生、轴突引导、树突发育、神经肌肉接头、神经营养素和其他神经学研究的研究。
单克隆抗体可用于识别与免疫反应相关的各种细胞类型,并了解此类反应背后的机制。此外,单克隆抗体还用于研究T细胞和B细胞在发育过程中的变化。由于其结合特异性,抗体可用于各种诊断测定,例如感染检测、过敏识别以及血液样本中激素的测量,它们也被用作血液中的生物标记。单克隆抗体的主要优点之一是它们可以非常便宜地大规模生产。单克隆抗体目前经常被用作实验室的探针,以揭示许多疾病的发病途径,无论是癌症、阿尔茨海默病还是自身免疫性疾病。单克隆抗体对于器官移植组织和移植血液的分型也至关重要,因此还被用来分析体液以进行诊断和监测医院感染。
华安生物产品在研究中的优势
研究人员在涉及抗体的研究中面临许多挑战,特别是由于抗体供应商提供的抗体质量问题。另一个问题是缺乏有关抗体生产方法的基本信息。华安生物的抗体具有特异性强、稳定性高的特点,作为追求卓越的抗体制造商,我们会检测每一个新批次的抗体产品,将最新批次与之前的批次进行比较,使用相同的实验条件来审查活性和特异性是否一致。除此之外,华安生物经过16年的不懈的坚持和努力,建立起了行业技术领先的兔单B抗体开发技术,其中包括了高通量的重组蛋白开发流程。公司的目录产品包括重组兔单抗、小鼠单抗、兔多抗、羊驼抗体、荧光直标抗体、二抗、细胞因子/蛋白、ADC药品小分子检测抗体、Elisa Kit等,产品质量得到了全球顶尖科学家们的高度认可。多名博士组成的科学家团队专攻抗体结构改造及深加工,拥有一系列有自主专利保护的技术和流程。公司通过了ISO9001和ISO13485质量体系认证,既保证了科学的严谨性,又有效地控制了项目周期和成本。

浙公网安备 33019202000643号